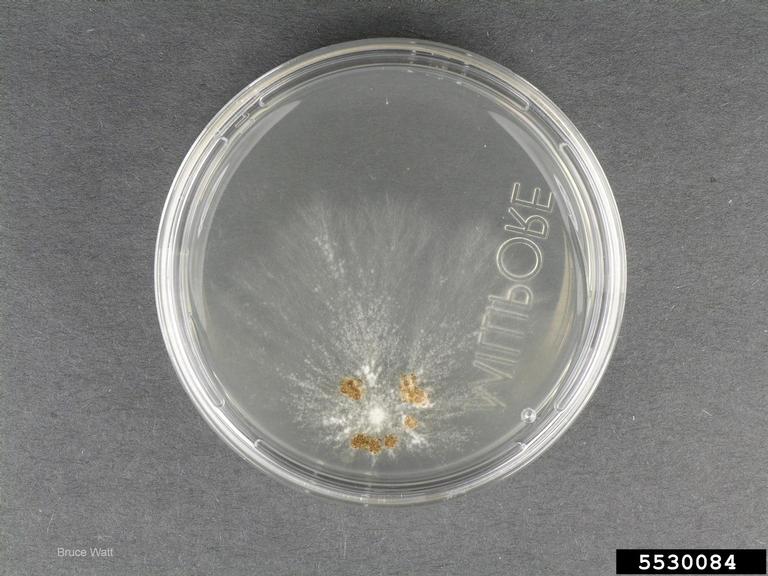

Image Number: 5530084
Photographer:
Organization:
Descriptor:
Culture
Description:
Culture from a sclerotium on 1/2 PDA
Image type:
Laboratory
Host:
You must attribute the work in the manner specified (but not in any way that suggests endorsement). You may not use this work for commercial purposes unless permission is granted by the photographer or copyright owner.
Image location:
, Kennebec County, ME
Subject
| Kingdom: Fungi |
| Phylum: Basidiomycota |
| Subphylum: Hymenomycotina |
| Class: Agaricomycetes |
| Subclass: Agaricomycetidae |
| Order: Agaricales |
| Family: Typhulaceae |
| Genus: Sclerotium |
| Subject: Sclerotium spp. |
Host
| Kingdom: Plantae |
| Phylum: Magnoliophyta |
| Class: Magnoliopsida |
| Subclass: Asteridae |
| Order: Solanales |
| Family: Polemoniaceae |
| Genus: Phlox |
| Subject: Phlox spp. L. |
Node Affiliation:
Image uploaded:
Sunday, March 29, 2015
Image last updated:
Thursday, April 2, 2015